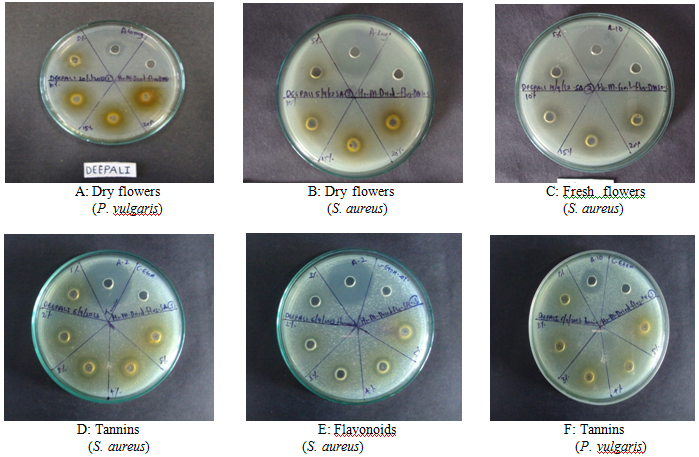
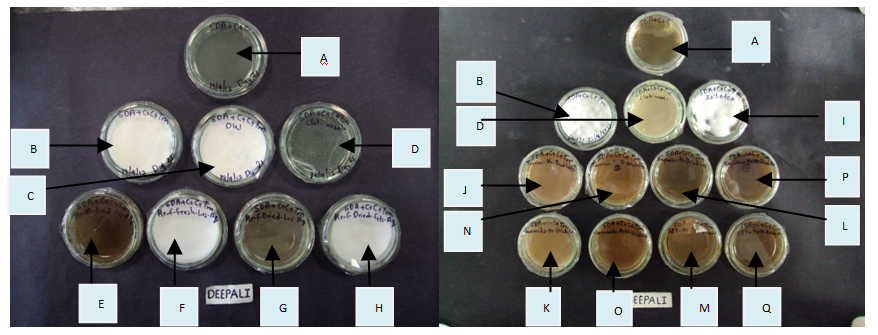

Int J Pharm Pharm Sci, Vol 6, Issue 11, 237-243Original Article
PHYTOCHEMICAL INVESTIGATIONS AND ANTIMICROBIAL AND ANTICANCER ACTIVITIES OF HOMONOIA RIPARIA LOUR.
UJWALA CHINTAMANI BAPAT*, DEEPALI RAVINDRA MHAPSEKAR
Department of Botany, St. Xavier’s College, Mahapalika Marg, Mumbai 400001, Maharashtra State, India.
Email: ucbapat@gmail.com
Received: 22 Sep 2014 Revised and Accepted: 20 Oct 2014
ABSTRACT
Objective: Present study aims at the evaluation of antibacterial activity against Escherichia coli, Proteus vulgaris, Staphylococcus aureus and Bacillus cereus, antifungal activity against Trichophyton mentagrophytes and T. rubrum and anticancer activity against human lung cancer cell line - A549 of extracts of Homonoia riparia Lour. The extracts showing antimicrobial activity were further subjected to phytochemical analysis to determine the major group of compounds present.
Methods: The procedures used for testing the antimicrobial and anticancer activity were as per the prescribed methods.
Results: DMSO extracts of male flowers inhibited growth of P. vulgaris and S. aureus whereas, aqueous extracts of both leaves and male flowers inhibited growth of T. mentagrophytes. Phytochemical analysis of these extracts showed the presence of tannins, saponins and flavonoids in leaves and flowers. Tannins, saponins and flavonoids were separated by traditional extractive methods. MIC of tannins from flowers was 50 mg ml-1against P. vulgaris and of tannins and flavonoids was 40 mg ml-1against S. aureus. The extracted tannins, flavonoids, saponins and steroids and triterpenoids from leaves and flowers inhibited the growth of T. mentagrophytes. TLC of these compounds showed presence of a few common components in the leaves and flowers.
The ethanolic extracts of H. riparia did not exhibit anticancer activity.
Conclusion: The leaves and male flowers of H. riparia possess antimicrobial activity. The tannins, flavonoids, saponins, steroids and triterpenoids are present in leaves and flowers and inhibit the growth of P. vulgaris, S. aureus and T. mentagrophytes.
Keywords: Homonoia riparia, Escherichia coli, Proteus vulgaris, Staphylococcus aureus, Bacillus cereus, Trichophyton mentagrophytes, Trichophyton rubrum, antimicrobial activity.
INTRODUCTION
Herbal medicines have been widely used and now form an integral part of the primary healthcare in many countries. They may constitute a reservoir of new antimicrobial substances to be discovered [1]. The plants of family Euphorbiaceae are traditionally used to cure several diseases. Homonoia riparia Lour. is well known for its medicinal properties. The powdered root of the plant is laxative, diuretic and emetic. A decoction of the root is given for piles, stones in bladder, chest pain, gonorrhoea and syphilis. Powdered leaves and fruits are applied as poultice for skin diseases [2]. Although H. riparia has medicinal properties, there are very few reports on the antimicrobial activity and the phytoconstituents [3, 4] present in this plant.
Present study aims at the evaluation of antibacterial, antifungal and anticancer activities of extracts of H. riparia and the chemical examination of its dry leaves and male flowers for their phytoconstituents.
MATERIALS AND METHODS
Collection, authentication, drying and powdering of plant material and preparation of extracts
The plant material was collected from Sanjay Gandhi National Park, Borivali, Mumbai and was identified and authenticated referring to the floras and Blatter herbarium specimen. The plant materials were washed under running water, dried in the shade, segregated in root, leaves, flowers and fruits and powdered and sieved (mesh size 1 mm) separately. 20 % extracts of the fresh and dry plant materials were prepared in different solvents (distilled water, ethanol, methanol, petroleum ether and DMSO) by crushing them separately in case of extracts of fresh materials and by separately soaking them overnight in different solvents. The extracts were filtered through Whatman No. 1 filter paper. The filtrates were then passed through Millipore filter (0.45 µm) and used for further study. The extracts were prepared in triplicates.
Antimicrobial activity studies
Antibacterial activity assay and determination of Minimum Inhibitory Concentration (MIC) of extracts
The antibacterial activity of the extracts of H. riparia was tested by the disc diffusion method [5, 6] with amoxycillin-10 mcg/ disc as the antibiotic (positive control) obtained from Hi-Media Laboratories Pvt. Ltd., Mumbai, India. Sterile Whatman No.1 filter paper discs (6.00 mm diameter) was dipped in different extracts, solvent (served as negative control) and amoxycillin. They were placed on the Nutrient agar plates inoculated separately with Escherichia coli (NCIM No. 2931), Proteus vulgaris (NCIM No. 2813), Staphylococcus aureus (NCIM No. 5021) and Bacillus cereus (NCIM No. 2106). The plates were incubated at 30+2 0C and the microbial growth was checked after 24 hrs. The diameter of zone of inhibition (ZOI) was noted. The MIC of extracts inhibiting the growth of organisms (i. e. diameter of ZOI > 10) was determined by testing 5 %, 10 %, 15 % and 20 % extracts using pour plate method [7, 8](with 6.0 mm wells each with 20 µl of extract). Two µg/ 20 µl of amoxycillin was used for S. aureus and 10 µg for E. coli, P. vulgaris and B. cereus. The antibacterial activity and MIC of extracted flavonoids and saponins and the 70 % ethanolic extract (used for analysis of steroids and triterpenoids) reconstituted in 20 % ethanol; and the extracted tannins reconstituted in 100 % ethanol, obtained from dry male flowers was determined by pour plate method. The results are expressed as mean value of ZOI in mm + standard error.
Antifungal (antidermatophytic) activity assay
The antifungal activity of the extracts was tested by the methods prescribed by Abubacker et al (2008) and Webster et al (2008)[9, 10]. One ml of 20 % extracts of fresh and dry entire plant, roots, leaves, male flowers and fruits prepared in distilled water (DW) and ethanol (20 % EtOH) were added separately to four ml of SDA medium supplemented with cycloheximide and chloramphenicol obtained from Hi-Media Laboratories Pvt. Ltd., Mumbai, India [11, 12]. 0.2 ml (about 0.25 –0.40 x 106spores/ ml) of fungal spore suspension of Trichophyton mentagrophytes and T. rubrum was transferred separately on the plates and spread evenly. 10 mg/ ml of Clotrimazole solution (Canesten obtained from Bayer Pharmaceuticals Pvt. Ltd., India) was used as standard antifungal agent. The plates were incubated at 30+2 0C for 21 days and they were checked every day for fungal growth (if any). The antifungal activity of extracted tannins, flavonoids, saponins and the 70 % ethanolic extract reconstituted in 20 % ethanol (used for analysis of steroids and triterpenoids) from the dry leaves and flowers was also determined.
Study of anticancer activity
5 % ethanolic extracts of the dry roots, leaves and male flowers (Sample Codes A, B and C respectively) were tested for in vitro anticancer activity against human lung cancer cell line - A549 (derived from NCCS, Pune) using Sulforhodamine B assay [Gaidhani et al (2009)]at Advanced Centre for Treatment Research and Education in Cancer(ACTREC), Navi Mumbai [13]. DMSO was used as the vehicle by dissolving residues of the dried ethanolic extracts in it and 10, 20, 40 and 80 µg/ ml of these extracts were analysed. Adriamycin or doxorubicin was used as the positive control drug. The parameters reported being GI50, TGI and LC50. All the GI50 values are averages of three experiments.
Phytochemical screening
Plant extracts exhibiting antimicrobial activity were screened for the presence of different classes of compounds including tannins, flavonoids, alkaloids, saponin glycosides, steroids and triterpenoids, carbohydrates and proteins following standard methods [14-16].
Extraction of tannins, flavonoids and saponins and preparation of extract for the analysis of steroids and triterpenoids
The amount of total tannins was determined by following the method used by Brindha et al [17]. Total flavonoids and saponins were estimated by the methods followed by Edeoga et al [18] and Malu et al [19] respectively. The extract was prepared for analysis of steroids and triterpenoids following the method of Bai et al [20].
The total tannin, flavonoid and saponin contents were calculated as follows:

Separation of components by TLC
The residues of extracted flavonoids, steroids and triterpenoids were dissolved in 20 % ethanol and those of tannins and saponins were dissolved in 100 % ethanol and used for TLC. These extracts were applied on TLC plates [Silica gel 60 F 254 of E. MerckKGaA] using CAMAG Linomat IV HPTLC applicator. The pre-saturation time was 45 min for tannins, 20 min for saponins and 10 min for flavonoids, steroids and triterpenoids.
The run distance was 80 mm. The plates were scanned at 200 nm, 254 nm and 366 nm before derivatization and at 366 nm and 540 nm after derivatization. The Rf values were measured using CAMAG TLC scanner. The mobile phases and spraying reagents are given in table 1. The track positions and volume of extracts loaded on the TLC plates are given in table 2.
Table 1: Mobile phases and spraying reagents for TLC
| Compound | Mobile phase | Ratio of Mobile phase | Spraying reagent |
| Tannins [21] | Toluene: Acetone: Formic acid (85%) | 6:6:1 | Alcoholic FeCl3 reagent |
| Flavonoids [22] | Ethyl acetate: Formic acid: Glacial acetic acid: Water | 10: 0.5: 0.5: 1.3 | Anisaldehyde sulphuric acid reagent |
| Saponins [23] | Chloroform: Acetic acid: Methanol: Water | 6.4: 3.2: 1.2: 0.8 | Anisaldehyde sulphuric acid reagent |
| Steroids [24,25] | n-butanol: Methanol: Water | 3: 1: 1 | 10% Sulphuric acid in methanol |
| Triterpenoids[26] | n-hexane: Ethyl acetate | 1: 1 | 10% Sulphuric acid in methanol |
Table 2: Track positions and volume of extracts of H. riparia
Sample |
Tannins |
Flavonoids, saponins, steroids and triterpenoids |
||||
Track no. |
Vol. of extracts µl |
Track no. |
Vol. of extracts µl |
Track no. |
Vol. of extracts µl |
|
Standard |
1 |
7 |
- |
- |
- |
- |
Leaves |
2 |
7 |
1 |
2 |
2 |
5 |
Male flowers |
3 |
7 |
3 |
2 |
4 |
5 |
RESULTS AND DISCUSSION
The collected plant specimen matched with the Blatter Herbarium specimen no. 68527.
Antimicrobial activity studies
Antibacterial activity assay and determination of MIC of extracts
The results of the antibacterial activity of the fresh and dry H. riparia are given in table 3. The aqueous, ethanolic, methanolic and petroleum ether extracts of entire plant, roots, leaves, male flowers and fruits did not inhibit the growth of any of the organisms tested.
The DMSO extract of dry male flowers inhibited the growth of P. vulgaris and S. aureus with diameter of zone of inhibition (ZOI) being the highest (17.00 mm) against P. vulgaris (Table 3). The MIC values obtained were 200 mg ml-1 (Table 4) (Figure 1. A and B respectively).
Antibacterial activity of the tannins, flavonoids, saponins and the 70 % ethanolic extract reconstituted in 20 % ethanol (used for analysis of steroids and triterpenoids) obtained from the male flowers is given in table 5. The minimum inhibitory concentrations for tannins and flavonoids are given in table 6.
It was observed that both the extracted tannins and flavonoids from the male flowers inhibited the growth of S. aureus, with the highest zone of inhibition of 12.00 mm (Table 5) for the latter. The MIC was found to be 40 mg ml-1 (Table 6) (fig. 1. D and E respectively). The growth of P. vulgaris was inhibited only by the extracted tannins with MIC of 50 mg ml-1 (fig. 1. F).
Antifungal activity assay
Aqueous extracts of dry leaves and male flowers of H. riparia inhibited the growth of the T. mentagrophytes among all the extracts tested (fig. 2. E and G respectively). The growth of T. rubrum was not inhibited by any of the extracts tested (Table 7).
There are no earlier reports on the antifungal activity of H. riparia against the dermatophytes. The extracted tannins, flavonoids and saponins and the 70 % ethanolic extracts reconstituted in 20 % ethanol (used for analysis of steroids and triterpenoids) showed the inhibition of T. mentagrophytes (Table 8) (fig. 2. J to Q).
Table 3: Antibacterial activity of extracts of fresh and dry H. riparia expressed as diameter of Zone of Inhibition (ZOI) in mm.
Organism |
Reference antibiotic |
Solvent Control |
Entire |
Roots |
Leaves |
Male Flowers |
Fruits |
|||||
Fr |
Dr |
Fr |
Dr |
Fr |
Dr |
Fr |
Dr |
Fr |
Dr |
|||
|
|
|
Aqueous extracts |
|||||||||
E. coli |
20.00 |
- |
- |
- |
- |
- |
- |
- |
- |
- |
- |
7.0 |
P. vulgaris |
18.14 |
- |
- |
- |
- |
- |
- |
- |
10.0 |
10.0 |
- |
- |
S. aureus |
39.57 |
- |
- |
- |
- |
- |
- |
- |
9.0 |
- |
- |
- |
B. cereus |
9.50 |
- |
- |
- |
- |
- |
- |
- |
- |
- |
- |
- |
|
|
|
Ethanolic extracts |
|||||||||
E. coli |
23.08 |
6.33 |
7.3 |
6.0 |
6.0 |
6.0 |
6.0 |
6.0 |
- |
- |
6.0 |
7.0 |
P. vulgaris |
16.57 |
8.0 |
- |
- |
7.0 |
- |
7.0 |
- |
10.0 |
10.0 |
7.0 |
- |
S. aureus |
39.29 |
- |
- |
- |
- |
- |
- |
- |
10.0 |
- |
- |
6.0 |
B. cereus |
10.52 |
6.0 |
6.0 |
- |
6.0 |
6.0 |
8.0 |
- |
- |
- |
6.0 |
- |
|
|
|
Methanolic extracts |
|||||||||
E. coli |
21.60 |
7.0 |
7.3 |
8.0 |
6.0 |
6.0 |
- |
6.0 |
- |
7.0 |
6.0 |
6.0 |
P. vulgaris |
14.57 |
6.0 |
- |
- |
- |
- |
- |
8.0 |
10.0 |
7.0 |
- |
7.0 |
S. aureus |
39.29 |
- |
- |
- |
- |
- |
- |
- |
10.0 |
- |
- |
- |
B. cereus |
10.40 |
6.0 |
6.0 |
6.0 |
- |
6.0 |
6.0 |
6.0 |
- |
- |
- |
6.0 |
|
|
|
Petroleum ether extracts |
|||||||||
E. coli |
21.90 |
6.0 |
6.0 |
6.0 |
6.0 |
6.0 |
- |
6.0 |
- |
- |
- |
6.0 |
P. vulgaris |
16.57 |
- |
- |
- |
- |
- |
- |
- |
- |
- |
- |
- |
S. aureus |
39.57 |
- |
- |
- |
- |
- |
- |
- |
- |
- |
- |
- |
B. cereus |
14.50 |
6.0 |
6.0 |
6.0 |
- |
6.0 |
- |
6.0 |
- |
- |
- |
6.0 |
|
|
|
DMSO extracts |
|||||||||
E. coli |
19.00 |
6.0 |
6.0 |
- |
6.0 |
- |
6.0 |
- |
- |
8.0 |
- |
- |
P. vulgaris |
13.29 |
- |
- |
- |
- |
- |
7.0 |
7.0 |
10.0 |
17.0 |
- |
7.0 |
S. aureus |
39.14 |
- |
- |
- |
- |
- |
- |
6.0 |
11.0 |
12.0 |
- |
7.0 |
B. cereus |
10.00 |
6.0 |
9.0 |
6.0 |
6.0 |
7.0 |
10.0 |
8.6 |
10.0 |
6.0 |
6.0 |
9.0 |
Table 4: Determination of MIC of extracts of male flowers of H. riparia*.
Male Flowers |
Amoxycillin |
Solvent control |
DMSO extracts |
|||
5% |
10% |
15% |
20% |
|||
|
|
|
P. vulgaris |
|||
Dry |
13.67+1.45 |
- |
8.00+0.00 |
9.67+0.66 |
11.00+0.58 |
12.00+0.58 |
|
|
|
S. aureus |
|||
Fresh |
25.00+0.00 |
- |
10.67+0.33 |
11.00+0.00 |
11.33+0.33 |
11.33+0.33 |
Dry |
26.00+0.00 |
- |
9.33+0.33 |
10.00+0.58 |
10.00+0.58 |
11.33+0.33 |
* - Values in the table are ZOI in mm with + standard error.
Table 5: Antibacterial activity of 70 % ethanolic extracts and extracts of tannins, flavonoids and saponins of male flowers.
Organism |
Amoxycillin |
Solvent Control |
ZOI in mm |
|||
Tannins in 100% ethanol |
Flavonoids in 20% ethanol |
Saponins in 20% ethanol |
70% ethanolic extract reconstituted in |
|||
P. vulgaris |
21.33 |
- |
11.00 |
- |
- |
- |
S. aureus |
27.25 |
- |
11.00 |
12.00 |
- |
8.00 |
Table 6: Determination of MIC of the extracted tannins and flavonoids (Diameter of ZOI in mm)*.
| Extract of compound | Organism | Amoxycillin | Solvent Control | 1% | 2% | 3% | 4% | 5% |
| Tannins | P. vulgaris | 15.00+0.00 | - | 9.67+0.66 | 10.00+1.00 | 11.00+0.58 | 11.00+1.00 | 11.67+0.66 |
| S. aureus | 27.67+0.33 | - | 10.33+0.33 | 11.33+0.33 | 12.00+0.00 | 12.33+0.33 | 12.33+0.33 | |
| Flavonoids | S. aureus | 23.33+1.26 | - | 9.00+0.00 | 10.00+0.00 | 10.67+0.33 | 11.67+0.33 | 11.67+0.33 |
* - Values in the table are with + standard error.
Table 7: Antifungal activity of extracts of fresh and dry entire plant, roots, leaves, male flowers and fruits of H. riparia
Plant material |
Control |
T. mentagrophytes |
T. rubrum |
||||||||||
C1 |
C2 |
C3 (C1+ |
C4 |
C5 (C1 + Extracts) |
|||||||||
DW |
20% EtOH |
DW |
20% EtOH |
||||||||||
Fr |
Dr |
Fr |
Dr |
Fr |
Dr |
Fr |
Dr |
||||||
Entire |
- |
+ |
- |
- |
- |
- |
- |
- |
- |
- |
- |
- |
|
Roots |
- |
+ |
- |
- |
- |
- |
- |
- |
- |
- |
- |
- |
|
Leaves |
- |
+ |
- |
- |
- |
+ |
- |
- |
- |
- |
- |
- |
|
Male flowers |
- |
+ |
- |
- |
- |
+ |
- |
- |
- |
- |
- |
- |
|
Fruits |
- |
+ |
- |
- |
- |
- |
- |
- |
- |
- |
- |
- |
|
* = Cycloheximide, † = Chloramphenicol –, ‡= Ethanol, Fr = Fresh, Dr = Dry, + = Inhibition of dermatophytes, - = No inhibition of dermatophytes
Table 8: Antifungal activity of 70 % ethanolic extracts and the extracted tannins, flavonoids and saponins from the dry leaves and male flowers
Extracts of compounds |
Control |
T. mentagrophytes |
|||
|
C1 |
C2 |
C3 |
C4 |
|
Leaves |
Male flowers |
||||
Tannins |
- |
+ |
- |
+ |
+ |
Flavonoids |
- |
+ |
- |
+ |
+ |
Saponins |
- |
+ |
- |
+ |
+ |
70% ethanolic extracts reconstituted in 20 % ethanol |
- |
+ |
- |
+ |
+ |
Fig. 1: MIC of DMSO extracts of male flowers and extracted tannins and flavonoids against the growth of P. vulgaris and S. aureus.
(Ci= Cycloheximide, Cii = Chloramphenicol, Clo = Clotrimazole, DW = Distilled water, TM- T. mentagrophytes)
A. SDA + Ci + Cii, B. SDA+ Ci + Cii + TM, C. SDA +Ci + Cii + TM + DW D. SDA + Ci + Cii + TM + Clo, E. SDA + Ci + Cii + TM + DW extract of dry leaves, F. SDA + Ci + Cii + TM + DW extract of fresh leaves, G. SDA + Ci + Cii + TM + DW extract of dry male flowers, H. SDA + Ci + Cii + TM + DW extract of dry fruits, I. SDA +Ci + Cii + TM + 20% EtOH, J. SDA + Ci + Cii + TM + tannins extracted from dry leaves, K. SDA + Ci + Cii + TM + flavonoids extracted from dry leaves, L. SDA + Ci + Cii + TM + saponins extracted from dry leaves, M. SDA + Ci + Cii + TM + 70 % EtOH extract of dry leaves reconstituted in 20 % EtOH, N. SDA + Ci + Cii + TM + tannins extracted from dry male flowers, O. SDA + Ci + Cii + TM + flavonoids extracted from dry male flowers, P. SDA + Ci + Cii + TM + saponins extracted from dry male flowers, Q. SDA + Ci + Cii + TM + 70 % EtOH extract of dry male flowers reconstituted in 20 % EtOH
Fig. 2: Fig. 2: Effect of aqueous extracts of leaves and male flowers and extracted tannins, flavonoids, saponins and 70 % EtOH extracts on the growth of T. mentagrophytes.
Study of anticancer activity
The anticancer activity of the ethanolic extracts of roots, leaves and male flowers showed following results:
Table 9 shows that adriamycin showed 1.7 % of control growth of human lung cancer cell line A549 at 80 µg/ ml of drug concentration. However, the roots, leaves and flowers of H. riparia (Samples A, B and C respectively) showed 88.8 %, 66.1 % and 87.8 % respectively of control growth at 80 µg/ ml. The GI50 value of <10 in case of adriamycin indicated anticancer activity.
GI50 value of ≤ 20µg/ml is considered to demonstrate activity in case of extracts. The GI50 values obtained for the extracts of roots, leaves and flowers of H. riparia were > 80, indicating lack of demonstration of activity (Table 10). However, Spjut et al (2005) had observed the antitumour activity of H. riparia against Walker Carcinoma 256 tumours in the National Cancer Institute (NCI) Chemotherapy Screening Program [28]. Shu-min et al (2007) also isolated aleuritolic acid from the ethyl acetate extract of the roots which exerted weak activity against AGZY 83-a (human lung cancer cells) [4].
Table 9: The % control growth observed in human lung cancer cell line A549 for the drug concentrations (µg/ ml) in the extracts of H. riparia
Sample/ Standard |
(% Control Growth) |
|||||||||||||||
Experiment 1 |
Experiment 2 |
Experiment 3 |
Average Values |
|||||||||||||
10 |
20 |
40 |
80 |
10 |
20 |
40 |
80 |
10 |
20 |
40 |
80 |
10 |
20 |
40 |
80 |
|
A |
100.0 |
94.4 |
88.9 |
86.6 |
94.3 |
93.7 |
90.7 |
89.6 |
96.2 |
91.2 |
91.1 |
90.1 |
96.8 |
93.1 |
90.2 |
88.8 |
B |
82.8 |
81.5 |
80.7 |
67.8 |
87.5 |
83.1 |
76.5 |
64.0 |
92.3 |
87.7 |
76.0 |
66.7 |
87.5 |
84.1 |
77.7 |
66.1 |
C |
100.0 |
88.6 |
84.9 |
83.7 |
92.6 |
91.2 |
90.6 |
90.3 |
100.0 |
98.2 |
94.5 |
89.5 |
97.5 |
92.7 |
90.0 |
87.8 |
ADR |
8.6 |
4.3 |
3.9 |
2.6 |
9.0 |
5.6 |
4.4 |
1.5 |
26.2 |
7.5 |
5.9 |
1.2 |
14.6 |
5.8 |
4.7 |
1.7 |
*A – Roots, B- Leaves, C- Male flowers, ADR- Adriamycin
Table 10: LC50, TGI and GI50 values of the extracts of H. riparia
|
Drug concentrations (µg/ml) calculated from graph |
||
A549 |
LC50 |
TGI |
GI50 |
A |
>80 |
>80 |
>80 |
B |
>80 |
>80 |
>80 |
C |
>80 |
>80 |
>80 |
ADR |
>80 |
62.6 |
<10 |
Phytochemical screening
The preliminary phytochemical tests of extracts of leaves and male flowers of H. riparia were positive for tannins, flavonoids, saponin glycosides, steroids and triterpenoids, carbohydrates and proteins. Patil et al (2014) reported the presence of phenolics, alkaloids, fatty acids, lignin, resins, flavones, quinones, anthraquinones, cardiac glycosides, in addition to these compounds in the dry leaves of H. riparia [27]. There are no reports on the phytochemical analysis of male flowers.
Extraction and estimation of tannins, flavonoids and saponins
Since the crude extracts of leaves and male flowers showed presence of tannins, flavonoids and saponins, these compounds were extracted and their total contents were determined (Table 11).
Separation of components by TLC
The results of TLC for separation of components are mentioned in Tables 12 and 13.
Table 11: Total tannin, flavonoid and saponin contents in dry leaves and male flowers of H. riparia
| Plant material | Total tannin content (%) | Total flavonoid content (%) | Total saponin content (%) |
| Leaves | 1.80 | 31.16 | 6.65 |
| Male flowers | 11.26 | 24.64 | 9.05 |
Table 11 showed that the tannin and saponin contents in the male flowers were found to be more (11.26 % and 9.05 % respectively) than its leaves (1.80 % and 6.65 % respectively). On the other hand, it was observed that the leaves showed 31.16 % of flavonoids where as, the flowers had 24.64 % flavonoids.
Table 12: Number of bands observed in the TLC of compounds of H. riparia
Plant material |
No. of compounds (represented by bands) separated on TLC plates |
||||
Tannins |
Flavonoids |
Saponins |
Steroids |
Triterpenoids |
|
Leaves |
9 |
8 |
9 |
9 |
1 |
Male flowers |
5 |
7 |
11 |
6 |
2 |
Table 13: Common components in the extracts of leaves and male flowers of H. riparia on TLC plates
| TLC of compounds | Bands common in all the extracts |
| Tannins | 5 |
| Flavonoids | 5 |
| Saponins | 6 |
| Steroids | 5 |
| Triterpenoids | 1 |
Tables 12 and 13 indicate that several components of tannins (fig. 3), flavonoids (fig. 4), saponins (fig. 5), steroids (fig. 6) and triterpenoids (fig. 7) are present in the extracts of both leaves and male flowers. Parveen et al (1988) had isolated gallic acid, taraxerone and quercetin rhamnoside from the leaves of H. riparia[29].
 |
 |
| Fig. 3: Separation of tannins by TLC | Fig. 4: Separation of flavonoids by TLC |
 |
 |
| Fig.5: Separation of saponins by TLC | Fig. 6: Separation of steroids by TLC |
 |
|
| Fig. 7: Separation of triterpenoids by TLC |
CONCLUSION
Present study shows that the DMSO extract of the dry male flowers of H. riparia inhibited the growth of P. vulgaris and S. aureus with MIC of 200 mg ml-1. The DMSO extract of fresh flowers exhibited the inhibition of growth of S. aureus with MIC value of 150 mg ml-1. The aqueous extracts of dry leaves and male flowers inhibited the growth of T. mentagrophytes. The phytochemical analysis of these extracts indicated that the tannin and saponin contents were highest in male flowers whereas, the flavonoid content was highest in the leaves. TLC of extracted tannins showed presence of 5 common components, flavonoids 5, saponins 6, steroids 5 and the triterpenoids showed 1 common component in the leaves and flowers. Further studies on the isolation of the chemical compounds present in this plant should be carried out to test their antibacterial and antidermatophytic potential.
ACKNOWLEDGEMENT
The authors gratefully acknowledge University Grants Commission for the financial assistance provided through the grant of Major Research Project to carry out this work. The authors express their sincere thanks to Principal, St. Xavier’s College for providing the facilities. Thanks to Dr. Medhekar, Head of Skin and V. D. Department, G. T. hospital and Microbiologist, Dr. Miskeen of Dr. Miskeen’s Central Clinical Microbiology Laboratory, Thane for their valuable guidance.
CONFLICT OF INTERESTS
None to declare
REFERENCES
- Assob JC, Kamga HL, Nsagha DS, Njunda AL, Nde PF, Asongalem EA, et al. Antimicrobial and toxicological activities of five medicinal plant species from cameroon traditional medicine. BMC Complementary Altern Med 2011;11(70):1-11.
- National Institute of Science Communication, CSIR (IN). The Wealth of India-A Dictionary of Indian Raw Materials and Industrial Products, Raw Materials Vol. V: H-K. New Delhi: CSIR; 1959.
- Viswanadh GS, Ramaiah PA, Laatsch H, Maskey R. Chemical constituents of the heartwood and bark of Homonoia riparia. J Trop Med Plants 2006;7(2):267-73.
- Shu-min Y, Xi-kui L, Chen Q, Da-gang W, Da-yuan Z. Chemical constituents from the roots of Homonoia riparia. Acta Pharm Sin 2007;42(3):292-6.
- Auwal MS, Fatima AL, Shuaibu A, Ismaila AM, Kyari AS, Thaluvwa AB, et al. Phytochemical properties and effect of aqueous extract of Jatropha caucus root bark on some bacterial isolates. J Pharmacogn Phytother 2013;5(8):148-52.
- Aneja KR. Experiments in Microbiology, Plant Pathology and Tissue Culture. New Delhi: Wishwa Prakashan, A division of Wiley Eastern Limited; 1993.
- Hamid AA, Aiyelaagbe OO, Ahmed RN, Usman LA, Adebayo SA. Preliminary phytochemistry, antibacterial and antifungal properties of extracts of Asystasia gangetica Linn T. Anderson grown in Nigeria. Adv Appl Sci Res 2011;2(3):219-26.
- Beltagy AM. Investigation of new antimicrobial and antioxidant activities of Brassica rapa. Int J Pharm Pharm Sci 2014;6(6):84-8.
- Abubacker MN, Ramanathan R, Senthil Kumar T. In vitro antifungal activity of Cassia alata Linn. flower extract. Nat Prod Rad 2008;7(1):6-9.
- Webster D, Taschereau P, Rene BJ, Sand C, Rennie RP. Antifungal activity of medicinal plant extracts; preliminary screening studies. J Ethnopharmacol 2008;5(1):140-6.
- Nelson MM, Martin AG, Heffernan MP. Superficial fungal infections: Dermatophytosis, Onychomycosis, Tinea nigra and Piedra. In: Freedberg IM, Eisen AZ, Wolff K, Austen KF, Goldsmith LA, Katz SI, editors. Fitzpatrick’s Dermatology in General Medicine, Vol. II. 6th ed. United States of America: Mcgraw-Hill, Medical Publishing Division; 2003. p. 1989-92.
- Larone DH. Medically important fungi-a guide to identification. Maryland: Harper and Row Publishers; 1976.
- Gaidhani SN, GS Lavekar GS, Juvekar AS, Sen S, Singh A, Kumari S. In-vitro anticancer activity of standard extracts used in ayurveda. Pharmacognosy Magazine 2009;5(20):425-9.
- Harborne JB. Phytochemical Methods-A Guide to modern techniques of plant analysis. 3rd ed. New Delhi: Springer (India) Private Limited; 1998.
- Kokate CK, Purohit AP, Gokhale SB. Pharmacognosy. 39th ed. Pune: Nirali Prakashan; 2007.
- Sadasivam S, Manickam A. Biochemical methods. 3rd ed. New Delhi: New Age International (P) Ltd; 2008.
- Brindha S, Thamaraiselvi T, Maragathavalli S, Annadurai B, Gangwar SK. Studies on the chemical and medicinal value of Vitex negundo Linn. Int J Adv Biol Res 2012;2(2):298-301.
- Edeoga HO, Okwu DE, Mbaebie BO. Phytochemical constituents of some Nigerian medicinal plants. Afr J Biotechnol 2005;4(7):685-8.
- Malu SP, Obochi GO, Edem CA, Nyong BE. Effect of methods of extraction on phytochemical constituents and antibacterial properties of Tetrecarpidium conophorum seeds. Global J Pure Appl Sci 2009;15(3):373-6.
- Bai X, Qiu A, Guan J. Optimization of microwave-assisted extraction of antihepatotoxic triterpenoid from Actinidia deliciosa root and its comparison with conventional extraction methods. Food Technol Biotechnol 2007;45(2):174-80.
- Auribie MA. Antioxidant activity of tannin from Tamarix aphylla L. leaves. Basrah J Agric Sci 2011;24(1):406-10.
- Wagner H, Bladt S, Zgainski EM. Plant drug analysis-a thin layer chromatography atlas. Verlag: Springer; 1984.
- Wagner H, Bladt S. Plant drug analysis-A thin layer chromatography atlas. 2nd ed. Germany: Springer; 1996.
- Dinan L, Hramatha J, Lafont R. TLC of sterols, steroids and related triterpenoids. In: Waksmundzka-Hajnos M, Sherma J, Kowalska T, editors. Thin layer chromatography in phytochemistry. Boca Raton: CRC Press, Taylor and Francis Group; 2008. p. 581.
- Sherma J. Steroids. In: Sherma J, Fried B, editors. Handbook of thin layer chromatography. 3rd ed. New York: Marvel Dekker; 2003. p. 919.
- Schmitz D, Zapp J, Bernhardt R. Hydroxylation of the triterpenoid dipterocarpol with CYP106A2 from Bacillus megaterium. Federation Eur Biochem Soc J 2012;279:1663–74.
- Patil RS, Godghate AG, Sawant RS. Phytochemicals and antimicrobial activity of leaves of Homonoia riparia. Int J Pharm Bio Sci 2014;5(2):352-6.
- Spjut RW. Relationships between plant folklore and antitumour activity: an historical review. SIDA 2005;21(4):2205-41.
- Parveen N, Singh MP, Khan NU. Chemical examination of the leaves of Homonoia riparia Lour. (Euphorbiaceae). J Indian Chem Soc 1988;65(11):815-6.